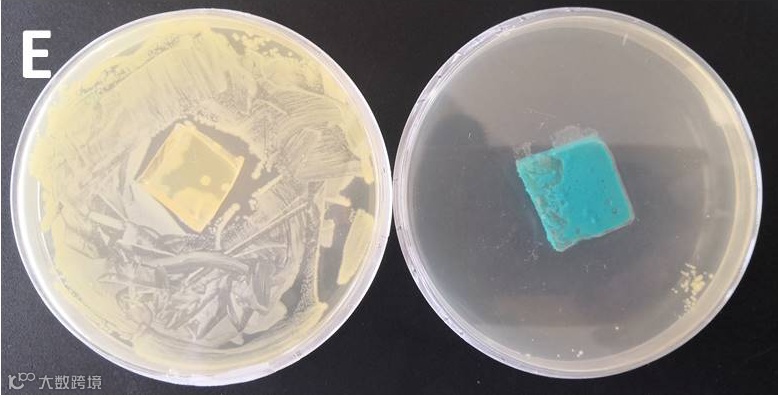

包膜控释肥能调控养分释放,提高肥料利用率和作物产量,并能有效减少养分损失对环境带来的负面影响。但是目前市场上的包膜控释肥采用的膜材大都来源于石油化工产品,价格昂贵、不易降解、不可再生。因此,来源广泛、可再生的的生物基膜材的研发成为热点。但是生物基膜材存在两大缺点:一是含有亲水基团易吸水;二是生物基原料在反应成膜过程中存在一些不参与反应成膜的物质,该不成膜物质在水分进入和养分溶出膜壳的过程中,会随溶液一起溶出膜外,导致膜壳孔隙增大或破裂,加速了养分释放,影响了其对养分的控释性能,是制约生产的瓶颈问题。
针对上述问题,杨越超教授团队从超疏水改性入手,以乙醇和水为溶剂,一步法合成了纳米月桂酸铜,并将该纳米材成功地用于对蓖麻油生物聚氨酯进行改性,然后对尿素肥料进行包膜,制得超疏水性改性的生物基包膜肥料(SBPCU)。相较于未改性的生物基包膜肥料(BPCU),SBPCU明显提升了控释特性,延长了释放周期。同时,利用X射线成像技术直接观测到超疏水表面与水接触面有一层空气层存在,该层空气层使水不能直接润湿膜材,只能以水分子的形式扩散进入膜内,从而能减缓水分进入和养分溶出膜外的速率,提升控释性能。



图1 超疏水纳米月桂酸铜改性生物基包膜控释肥制备示意图、空气膜图及超疏水增效原理图
另外,将该材料在纸、金属、玻璃、无纺布等不同基材上进行喷涂包衣,均可使这些材质表面具有超疏水性和超亲油性。采用该纳米材料包覆的无纺布和100目尼龙网可以对油水混合物进行有效地分离,具有极高的分离效率和可重复使用性。此外,该纳米材料表现出良好的抗菌能力和长期稳定性,因此该材料不仅可以应用于包膜控释肥料,还可以应用于各种防水涂层,油水分离和抑制土传病害等。总的来说,这种新型的纳米月桂酸铜是一种简单易得、低成本、多功能的涂层材料,在未来有广阔的应用前景。

图2 纳米月桂酸铜超疏水、油水分离及抑菌功能图示
但是,随着他们研究的深入,虽然可以通过上述的技术措施提高生物基膜壳的疏水性,克服其易亲水的缺点,但是很难大幅度的提高该类膜材的养分控释期。主要原因是生物基膜材中的不反应易溶物质的溶出,会导致膜壳孔隙增大或破裂,这就是即使采用超疏水改性,也很难大幅度提高控释性能的关键问题所在。因此,通过一系列的技术和手段,修复因不成膜物质溶出而导致的膜壳微孔通道增加或膜壳破损的问题,就成为提高该类产品质量的关键问题。如果该技术和机理机制得以阐明,也就解决了制约该类肥料产业化的瓶颈问题。针对这一关键问题,他们将膜材修复剂负载到中空纳米粒子中,然后将该类材料添加到生物基膜材中,在控释肥养分释放过程中,纳米粒子负载的修复剂逐渐释放到膜材中,与膜材中的固化剂迅速反应固化形成凝胶,实现堵孔,大幅升了包膜控释肥料的控释性能。从而实现生物基膜壳的自修复功能。









图3不同包膜肥料(A 3%,B 5%包膜含量)在25℃水中的氮释放曲线。自修复改性肥料自修复前(C1-C3)和自修复后(D1-D3)材料的扫描电镜;自修复原理图(E)。
以上相关成果分别发表在Journal of Materials Chemistry A (J. Mate. Chem. A 2019, 7, 9503–9509) 和ACS Applied Materials and Interfaces 上。论文的第一作者均为山东农业大学副教授张淑刚博士,通讯作者为杨越超教授。
原文链接:
https://dx.doi.org/10.1021/acsami.0c06530
相关进展
华南理工大学李红强副教授/曾幸荣教授课题组与美国康涅狄格大学孙陆逸教授课题组合作在可修复超疏水热致变色薄膜方面取得新进展
吉林大学李洋副教授团队:可室温修复化学和机械损伤的超疏水材料

高分子科技原创文章。欢迎个人转发和分享,刊物或媒体如需转载,请联系邮箱:info@polymer.cn


诚邀投稿
欢迎专家学者提供稿件(论文、项目介绍、新技术、学术交流、单位新闻、参会信息、招聘招生等)至info@polymer.cn,并请注明详细联系信息。高分子科技®会及时推送,并同时发布在中国聚合物网上。
欢迎加入微信群 为满足高分子产学研各界同仁的要求,陆续开通了包括高分子专家学者群在内的几十个专项交流群,也包括高分子产业技术、企业家、博士、研究生、媒体期刊会展协会等群,全覆盖高分子产业或领域。目前汇聚了国内外高校科研院所及企业研发中心的上万名顶尖的专家学者、技术人员及企业家。
申请入群,请先加审核微信号PolymerChina(或长按下方二维码),并请一定注明:高分子+姓名+单位+职称(或学位)+领域(或行业),否则不予受理,资格经过审核后入相关专业群。

点
这里“阅读原文”,查看更多


